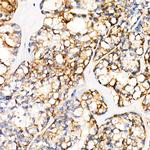
PGP9.5 Antibody in Immunohistochemistry (Paraffin) (IHC (P))

Search
Invitrogen
PGP9.5 Recombinant Rabbit Monoclonal Antibody (4F10B1)
{{$productOrderCtrl.translations['antibody.pdp.commerceCard.promotion.promotions']}}
{{$productOrderCtrl.translations['antibody.pdp.commerceCard.promotion.viewpromo']}}
{{$productOrderCtrl.translations['antibody.pdp.commerceCard.promotion.promocode']}}: {{promo.promoCode}} {{promo.promoTitle}} {{promo.promoDescription}}. {{$productOrderCtrl.translations['antibody.pdp.commerceCard.promotion.learnmore']}}
图: 1 / 12
PGP9.5 Antibody (MA5-35262) in ICC/IF

Please note: We are reviewing Western blot images included in the antibody testing data in our catalog, including those provided by third parties. Unless expressly labeled or annotated as “raw-unedited”, Western blot images included in the antibody testing data in our catalog may have been edited, optimized or otherwise adjusted for presentation.
产品信息
MA5-35262
种属反应
宿主/亚型
Expression System
分类
类型
克隆号
抗原
偶联物
形式
浓度
规格
纯化类型
保存液
内含物
保存条件
运输条件
RRID
产品详细信息
Immunogen sequence: MQLKPMEINP EMLNKVLSRL GVAGQWRFVD VLGLEEESLG SVPAPACALL LLFPLTAQHE NFRKKQIEEL KGQEVSPKVY FMKQTIGNSC GTIGLIHAVA NNQDKLGFED GSVLKQFLSE TEKMSPEDRA KCFEKNEAIQ AAHDAVAQEG QCRVDDKVNF HFILFNNVDG HLYELDGRMP FPVNHGASSE DTLLKDAAKV CREFTEREQG EVRFSAVALC
靶标信息
PGP9.5 (Protein gene product 9.5, UCH-L1, PARK5) is a neuron specific protein, structurally and immunologically distinct from neuron specific enolase. PGP9.5 has a molecular weight of 27 kDa and was first identified by high resolution two dimensional PAGE. PGP9.5 is a member of ubiquitin carboxyl-terminal hydrolase family 1 (peptidase family C12) with a ubiquitin carboxyl-terminal hydrolase domain. PGP9.5 is well known for having ubiquitin hydrolase and ligase activities that hydrolyzes small C-terminal adducts of ubiquitin to generate ubiquitin monomers. PGP9.5 is present in neurons and nerve fibers at all levels of the central and peripheral nervous system, in neuroendocrine cells, in segments of the renal tubules, in spermatogonia and Leydig cells of the testis, in ova and in some cells of both the pregnant and non-pregnant corpus luteum. Over expression of PGP9.5 leads to non-small cell lung cancer while decreased expression leads to Huntington disease and Alzheimer disease. Since PGP9.5 is present in cellular inclusions, it can be a useful as a neuronal marker and in the studies of neurodegenerative disorders such as with Parkinson disease.
仅用于科研。不用于诊断过程。未经明确授权不得转售。
篇参考文献 (0)
生物信息学
蛋白别名: gracile axonal dystrophy; Neuron cytoplasmic protein 9.5; OTTHUMP00000218137; OTTHUMP00000218139; OTTHUMP00000218140; OTTHUMP00000218141; PGP 9.5; PGP9.5; protein gene product 9.5; ubiquitin carboxy-terminal hydrolase L1; Ubiquitin carboxyl-terminal hydrolase isozyme L1; Ubiquitin thioesterase L1; UCH-L1; UCHL
基因别名: AW822034; C88048; gad; PGP 9.5; PGP9.5; R75593; UCH-L1; UCHL-1; UCHL1
UniProt ID: (Mouse) Q9R0P9, (Rat) Q00981
Entrez Gene ID: (Mouse) 22223, (Rat) 29545




